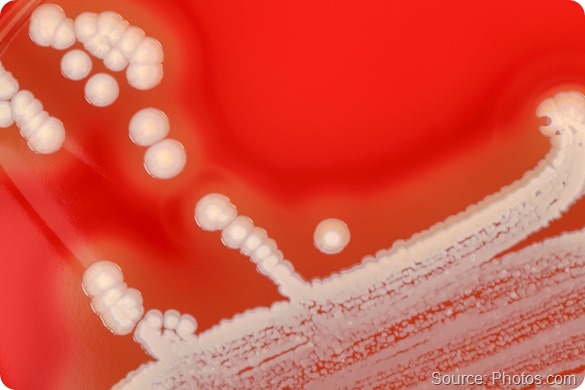
Bacterial colonies.

Chronic granulomatous disease, or CGD, is a diverse group of inherited diseases in which certain cells of the immune system have difficulty forming reactive oxygen compounds, most importantly superoxide radicals. These are used by these white blood cells to kill certain bacteria.
CGD leads to the individuals affected with this condition having chronic and repeated infections, and also the tendency to form what are called "granulomas.".
At least in this country, in the US, there are about one in two hundred thousand people who are affected by CGD, and there are about twenty new cases a year.

Which groups of mice were compared in your study and why?
The white blood cell kills bacteria through basically two types of mechanisms:
-
One is an oxidative mechanism, which is defective in patients with CGD.
-
The other is a non-oxidative mechanism which involves the use of certain proteases - that is, enzymes that cleave essential proteins that are necessary for bacterial survival.
We had found in previous studies that our protein, olfactomedin-4, can enhance white cell function when it is deleted. Olfactomedin-4, also called Olfm4, puts the brakes on the ability of the white blood cells to rapidly respond to and destroy bacteria. Therefore, if one deletes the protein, one has a more efficient way of killing a wide variety of bacteria.
We had shown in previous studies that these bacteria include fairly common bacteria: Staphylococcus aureus, E. coli, Klebsiella, and Helicobacter, for example. What we didn't know is whether the white blood cells were killing these bacteria solely through these pathways, or whether maybe it also involved this oxidative mechanism.
So the study that we did linked the observation that these individuals with CGD completely lacked the oxidative mechanism of killing bacteria.
We set up a series of experiments in which we created mice that were completely deficient in our protein, olfactomedin-4, and we bred those with mice that were completely deficient in this oxidative pathway.
What we created was basically three types of mice. We had normal mice that had both the oxidative pathway and the non-oxidative pathway intact. We had one group of mice that were deficient in the oxidative pathway alone. We had a third group that were deficient in the non-oxidative, the olfactomedin. And we had a fourth group, actually, which were deficient in both.
Essentially, what we were able to show is that, if one lacks both pathways, one can in fact enhance the ability of normal - as well as chronic granulomatosis disease-deficient - mice at killing bacteria and in fact improving their survival once they are injected with these lethal bacteria.
Please can you tell us more about Olfm4, also known as olfactomedin-4, and the role it is thought to play in the body?
We identified olfactomedin-4 a number of years ago, through studies in our laboratory in which we were looking for genes or proteins that are expressed very early in the process of what we call “lineage-specific differentiation."
I'm a blood specialist, a hematologist, and we know that in the bone marrow, for example, there are these bone marrow stem cells that can ultimately divide and give rise to white blood cells, red blood cells, and platelets. We were looking for the various early markers which specified which one of those pathways, or "lineages," those stem cells would commit to.
One of these proteins we found to be an early marker of white cell or myeloid development was something we originally termed HGC1. We later recognized this protein to be the olfactomedin-4 protein, so we subsequently changed the name to Olfm4.
Now, this protein was not only expressed in white cells, but at least in animal and in tissue samples, we found Olfm4 throughout the gastrointestinal tract, in the prostate, in the kidneys, and in a few other places. But Olfm4 was fairly limited in its expression.
By working out what Olfm4’s role was in white blood cells, we came to conclude that it was a protein inside the cells, which presumably had evolved, in part, to put the brakes on the acute inflammatory response that may limit tissue destruction once white cells are turned on because they're engulfed in bacteria and other pathogens.
By putting the brakes on that response, you can still allow for certain amounts of killing, but the white cells don't go on to kill or destroy normal tissue in the surrounding area. We think that's Olfm4’s main role: it inhibits a number of proteins or proteases that are inside the white blood cells. This leads to a fairly efficient destruction of bacteria that these white blood cells ingest.
Your research revealed that white blood cells in mice without Olfm4 could better withstand staphylococcus aureus infection, a major threat to patients with CGD. How do you think this result can be explained?
Well, what we found was that olfactomedin-4 binds to and inhibits critical proteases that are enzymes that chew up and cleave essential proteins necessary for bacterial function. So as these white cells ingest the bacteria, these proteases can begin to destroy the bacteria.
The Olfm4 protein binds to one particular protease, Cathepsin-C, and modulates its ability. This means that the protein is not left at its will to begin to destroy other proteins in the surrounding tissue.
And that protein itself, as it turns out, can activate other proteins that have similar effects. That's how it really functions. That's one essential consequence.
The other thing is that Olfm4 actually can loop back and turn off another critical protein called NF-Kappa-B. This protein is really essential because it's really at the heart of a lot of inflammatory processes. So when this protein is genetically deleted, which is what we did in these mice, that ability for those proteases is enhanced.
Secondly, this critical protein, NF-Kappa-B, is not turned off, and therefore, that leaves intact other processes, so-called inflammatory phytokines that are activated. These processes have the ability to rid the body more effectively of bacterial invasions and, in particular Staphylococcus aureus.
Do you think your findings will trigger new treatments for CGD?
There's a fairly good possibility that it would. Certainly one has to now begin to think about looking at small molecules, or even an antibody, that can over the course of a few days or a week inhibit olfactomedin-4's effect so that one can more rapidly clear bacteria, especially bacteria that are now becoming more resistant to the types of antibiotics that we have available.
Does your research shed any light on how to treat methicillin-resistant staphylococcus aureus (MRSA)?
We had tested in this animal model a common variety of Staphylococcus aureus. This gave us a good opportunity to look to see whether the effect would be more generalizable by using a type of bacteria that has become quite problematic these days - the so-called Methicillin-resistant Staph aureus, or MRSA. In the press, this is frequently referred to as "flesh-eating bacteria." And in fact, in a parallel experiment in which we compared the white cells of these olfactomedin-deficient animals - their ability to kill normal Staphylococcus aureus versus this Methicillin-resistant Staph aureus – the white cells did it equally effectively.
In fact, in further experiments that have been reported in this paper, if you inject the animals "intraperitoneally" (you put the bacteria directly into their peritoneum) and observe them over the next one to two weeks, this intraperitoneal injection of both normal Staphylococcus aureus as well as Methicillin-resistant Staph aureus are associated with very rapid fatality.
In contrast, the mice that are deficient in olfactomedin-4 can not only lead to a rapid clearance of the normal Staphylococcus aureus and the Methicillin-resistant, but between 95 to 100% of these animals survive for the period of observation.
So again, developing a compound that can transiently inhibit olfactomedin-4 activity in white cells might not only be useful for patients with chronic granulomatosis disease, or CGD, but it may also be applied as a strategy, in addition to antibiotic treatment, for patients that have these increasingly antibiotic-resistant strains of bacteria that are becoming much more common.
What impact could this have on combating antibiotic resistance as a whole?
Well, we have found, again, in previous studies that this approach is more generalizable, as I've indicated. Not only does it seem to be effective in Staphylococcus aureus, but also in E. coli. We've tried it in Klebsiella, as well as helicobacteria.
So far we have relied on more conventional strains of bacteria. We will use the same type of approach, as we did with the Staphylococcus aureus (methicillin-resistant) to look to see whether, again, this effect is quite generalized. There's every reason to believe that it would be generalizable, because all of these bacteria rely upon key proteins inside of them to maintain their ability to divide and invade the tissue. So by enhancing the proteins and proteases inside the white cells to destroy these bacteria, it's quite likely that this is more generalizable but again, we will have to test that specifically.
What we know right now is that this approach seems to achieve an effect in Methicillin-resistant Staphylococcus aureus. So we'll just have to test it in these other resistant strains as well.

What excites you most about your current research?
I'm very excited about the fact that this may allow a different approach. Many serious infections that we see in hospitals only happen in very old people, or for example, newborns, or in patients whose cancers have compromised their immune systems.
MRSA and these other infections not only occur in those patients, but they also affect healthy people. They're quite frequently picked up in the community, in kids in high school gymnasiums or in other crowded places. These bacterial infections, even in these healthy individuals, can be life-threatening. So coming up with a new strategy, a new armamentarium, something additional to add to antibiotic therapy, is a very exciting approach.
What are your further research plans?
Well, the research that we're currently conducting is, again, to confirm that in this animal model, that in fact these other resistant strains can be effectively destroyed and removed from this mouse model because of the enhanced ability of the white cells to destroy bacteria, so we'll be able to generalize it.
But secondly and in parallel, we’re now beginning to screen libraries of compounds - about thirty thousand compounds that are currently available - to see whether any of these compounds might turn off or diminish olfactomedin-4 activity, similar to what we’ve done genetically in these mice.
Because if we can find these compounds, then one can begin to test these compounds in animal models, and ultimately, if the compounds are effective, we can come up with strategies to begin determining their effects in humans, and then, ultimately, it may be applied. But again, this is still theoretical. We're quite likely to be years away from this type of advance. At least it really shines a spotlight on a potentially exciting new therapeutic strategy.
Where can readers find more information?
The paper was published in the Journal of Clinical Investigation: http://www.jci.org/articles/view/68453
More information on NIDDK: http://www2.niddk.nih.gov/
About Dr Griffin Rodgers
 Dr. Griffin P. Rodgers was named Director of the National Institute of Diabetes and Digestive and Kidney Diseases (NIDDK)--one of the National Institutes of Health (NIH)--on April 1, 2007. He had served as NIDDK’s Acting Director since March 2006 and had been the Institute’s Deputy Director since January 2001. As the Director of NIDDK, Dr. Rodgers provides scientific leadership and manages a staff of over 600 employees and a budget of $2.0 billion.
Dr. Griffin P. Rodgers was named Director of the National Institute of Diabetes and Digestive and Kidney Diseases (NIDDK)--one of the National Institutes of Health (NIH)--on April 1, 2007. He had served as NIDDK’s Acting Director since March 2006 and had been the Institute’s Deputy Director since January 2001. As the Director of NIDDK, Dr. Rodgers provides scientific leadership and manages a staff of over 600 employees and a budget of $2.0 billion.
Dr. Rodgers received his undergraduate, graduate and medical degrees from Brown University in Providence, R.I. He performed his residency and chief residency in internal medicine at Barnes Hospital and the Washington University School of Medicine in St. Louis. His fellowship training in hematology was in a joint program of the NIH with George Washington University and the Washington Veterans Administration Medical Center . In addition to his medical and research training, he earned an MBA, with a focus on the business of medicine/science, from Johns Hopkins University in 2005.
As a research investigator, Dr. Rodgers is widely recognized for his contributions to the development of the first effective — and now FDA approved — therapy for sickle cell anemia. He was a principal investigator in clinical trials to develop therapy for patients with sickle cell disease and also performed basic research that focused on understanding the molecular basis of how certain drugs induce gamma-globin gene expression. Recently, he and his collaborators have reported on a modified blood stem-cell transplant regimen that is highly effective in reversing sickle cell disease in adults and is associated with relatively low toxicity. He has been honored for his research with numerous awards including the 1998 Richard and Hinda Rosenthal Foundation Award, the 2000 Arthur S. Flemming Award, the Legacy of Leadership Award in 2002 and a Mastership from the American College of Physicians in 2005.
Dr. Rodgers has been an invited professor at medical schools and hospitals both nationally and internationally. He has been honored with many named lectureships at American medical centers and has published over 200 original research articles, reviews, and book chapters, has edited four books and monographs, and holds 3 patents.
Dr. Rodgers is a member of the American Society of Hematology, the American Society of Clinical Investigation, the Association of American Physicians, the American Academy of Arts and Sciences, and the Institute of Medicine of the National Academy of Science, among others. He served as Governor to the American College of Physicians and as Chair of the Hematology Subspecialty Board and a member of the American Board of Internal Medicine Board of Directors.